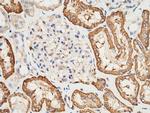
CD98 Antibody in Immunohistochemistry (Paraffin) (IHC (P))

Search
Invitrogen
CD98 Polyclonal Antibody
{{$productOrderCtrl.translations['antibody.pdp.commerceCard.promotion.promotions']}}
{{$productOrderCtrl.translations['antibody.pdp.commerceCard.promotion.viewpromo']}}
{{$productOrderCtrl.translations['antibody.pdp.commerceCard.promotion.promocode']}}: {{promo.promoCode}} {{promo.promoTitle}} {{promo.promoDescription}}. {{$productOrderCtrl.translations['antibody.pdp.commerceCard.promotion.learnmore']}}
图: 1 / 4
CD98 Antibody (PA5-81031) in IHC (P)

产品信息
PA5-81031
宿主/亚型
分类
类型
抗原
偶联物
形式
浓度
保存条件
运输条件
RRID
产品详细信息
This product is preservative free. It is recommended to add sodium azide to avoid contamination (final concentration 0.05%-0.1%).
This antibody has specificity for Human CD98/SLC3A2.
靶标信息
CD98 (4F2) is a type II transmembrane glycoprotein which serves as the heavy chain of the heterodimeric amino acid transporters (HATs). CD98, linked to various light chains by disulfide bond, is responsible for cell surface expression and basolateral localization of this transporter complex in polarized epithelial cells and also interacts with beta1 integrins and increases their affinity for ligand. Besides its roles in amino acid transport, CD98 is thus involved in cell fusion and activation. It is implicated in regulation of cellular differentiation, growth and apoptosis.
仅用于科研。不用于诊断过程。未经明确授权不得转售。



